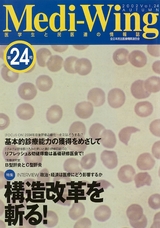
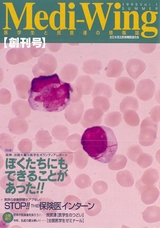

医学生向け情報誌メディウィングが電子ブックとしてイコリスでご覧いただけるようになりました。メディウィングは医学生をはじめ、医学を志す学生や学校の先生など多くの方にご購読頂いているフリーペーパーです。年三回発行しています。

- Medi-Wing
- 高校生向け
Medi-Wing egg - 家庭向け
Medi-wing home
- 【特集】
- 私たちはどう生きるか?①
~情報の洪水に流されないために - 【Close-up】
- 地域医療への情熱と今後求められる医師像
- 【医療研究室】
- 人を治して癒す、もう一つの医学
- 【連載】
- 羅針盤'25-「災害関連死」が明るみに、被災当時の神戸協同病院で何が起きたのか。
- 【特集】
- 祝、ノーベル平和賞受賞!
〜核兵器廃絶のバトンをつないで〜 - 【Close-up】
- 学生主体の奨学生活動
- 【医療研究室】
- マイナンバー保険証と受療権の問題
- 【連載】
- 羅針盤'25-「薬害エイズ」支援活動を通して学生時代に学んだこと
- 【特集】
- 助けてが言えない若者たち。
オーバードーズの背景に何があるのか - 【Close-up】
- PFASとは?
- 【医療研究室】
- 似顔絵セラピー
- 【連載】
- 羅針盤 '24-感謝の気持ちを胸に抱き、自分の想いを信じよう
- 【対談】
- 気候危機と健康格差 私たち学生/医療者にできること
- 【Close-up】
- 令和6年能登半島地震ー支え合う災害医療「困ったところに民医連あり」
- 【医療研究室】
- 子どもの性被害について【後編】
- 【連載】
- 羅針盤 '24-父の背中を追い続け、たどりついた場所
- 【対談】
- 気候危機と健康格差 私たち学生/医療者にできること
- 【Close-up】
- 令和6年能登半島地震ー支え合う災害医療「困ったところに民医連あり」
- 【医療研究室】
- 子どもの性被害について【後編】
- 【連載】
- 羅針盤 '24-父の背中を追い続け、たどりついた場所
- 【特集】
- おいでよ!民医連研修!!ー臨床研修病院の医師たちが語るプログラムの魅力
- 【Close-up】
- 変えるなら今でしょ!医師不足の現状と本当の働き方改革
- 【医療研究室】
- 子どもの性被害について【前編】
- 【連載】
- 羅針盤 '24-出会いの交差点 ケアを大切にする社会へ
- 【特集】
- 離島・へき地で医師になるー地域で求められる医師とは
- 【Close-up】
- 医師がいきいきと働き続けられる職場とは
- 【医療研究室】
- 医療現場で出あう“困った”を研究する
- 【連載】
- '23 出会いの交差点 理想の医師像と理想の社会を目指して
- 【特集】
- 知って納得!「憲法」ってなに?
- 【Close-up】
- お口の健康は体の健康~歯科酷書と医科歯科介護連携~
- 【医療研究室】
- Long COVID
- 【連載】
- 羅針盤'22 家庭医を目指す3つのきっかけ
- 【特集】
- 医療界のジェンダーギャップ それって当たり前!?
- 【Close-up】
- 格差社会、上から見るか?下から見るか?
- 【民連紹介】
- Let's Know!!民医連 -はじめまして民医連です‼-
- 【特集】
- ヤングケアラーを知ってほしい
目に見えない生きづらさを抱えた子どもたち - 【Close-up】
- 資本主義の仕組みと環境問題
- 【連載】
- 羅針盤'21 どんな医師になったらいいのか
- 【医療研究室】
- 新型コロナワクチン集団接種とその後
- 【特集】
- 新専門医制度のなかで揺れる研修医
- 【Close-up】
- 今あらためて問う、SNSとの向き合い方
- 【連載】
- 羅針盤'21 民医連と出会って、生き方が変わった!
- 【医療研究室】
- 受診を我慢します─コロナ禍で増えるメディカル・プアの現状
- 【特集】
- シリーズ「LGBT」Vol.2 誰もが当事者~医療者として、個人として向き合おう~
- 【医学業界を斬る!】
- 日本に巣くう鬼を暴く 働き方改革と医療現場
- 【医療研究室】
- 感染症パンデミックに対する国際的対応
<新型コロナウィルスと新型インフルエンザ> - 【特集】
- 新専門医制度
- 【Close-up】
- 戦争と日本の医療界
- 【診察室から】
- AdvanceCarePlanning
- 【連載】
- 羅針盤'20 民医連での初期研修と専門研修 ーたすきがけ研修を通してー
- 【特集】
- What is“Kyodo-Soshiki”? ー アメリカ人が語る「共同組織」と民医連
- 【Close-up】
- 外国人の医療事情
- 【連載】
- 羅針盤'19 「求められる」を大切に
- 【医療研究室】
- Social Vaital Signs:SVSとTeamSAIL
- 【特集】
- シリーズ「LGBT」Vol.1 ー ロバート・キャンベル氏インタビュー ー
- 【医学業界を斬る!】
- 医学部不正入試問題を斬る!
- 【医療研究室】
- ギャンブル依存症(病的賭博)とは
- 【連載】
- 羅針盤'19 「今できる精いっぱい」を続けて
- 【特集】
- SDHレポートinカナダ
- 【Close-up】
- AIは医療をどう変えるか
- 【医療研究室】
- 歯科酷書からみえる疾病と社会格差
- 【連載】
- 羅針盤'19 多職種の力で成り立つ医療 ー倫理カンファレンスの取り組みー
- 【特集】
- すぐそこにある病 事例から見える若者の貧困
- 【Close-up】
- AIは医療をどう変えるか
- 【医療研究室】
- 子どもを守る!小児虐待対策チーム
- 【連載】
- 羅針盤'18 民医連マニアの初期研修医、大いに夢を語ります
- 【特集】
- 日本×カナダ 家庭医トーク
患者のストーリーを聴きSDHに介入する - 【Close-up】
- Take it easy!~誰でもできる反核平和活動~
- 【連載】
- 羅針盤'18 求められることに応えようとする中で成長できる
現場はそんな学びがあふれている - 【医療研究室】
- 明日から役立つ!「動機づけ面接(MI)」
- 【特集】
- 治療だけでは救えないその人の生活 救急現場から見えるSDH
- 【医療業界を斬る】
- 医学科留年問題を斬る
- 【医療研究室】
- チームSTEPPSについて
- 【連載】
- 羅針盤'18─患者の思いを受け止め、社会にも目を向ける医師となってほしい
- 【特集】
- 民医連の医療と研修を考える 医学生のつどいって何?
- 【CLOSE UP】
- スポーツドクターしてみませんか?
- 【Medi-Wing初海外取材!!】
- SDH研究の最前線ハーバード大学 イチロー・カワチ教授[後編]
- 【連載】
- 羅針盤'17─激動の医学生時代を経て~民医連との出会い、3.11
- 【特集】
- SDH研究の最前線ハーバード大学 イチロー・カワチ教授
- 【CLOSE UP】
- 過労死するほど仕事があって、自殺するほど仕事が無い─他人事ではない若者の貧困
- 【医療研究室】
- ポリファーマシー
- 【連載】
- 羅針盤'17─出会いと別れから生じる物語
- 【特集】
- 「笑って死ねる病院」
実習レポート~患者さんと職員の“想い”を聴く~ - 【CLOSE UP】
- 震災の中に医師・看護師として立つ
- 【連載】
- 羅針盤'16─医療への長い航海に旅立つ君たちへ-仲間に支えられながら患者さんとともに
- 【医療研究室】
- 糖質制限食の誤解を解きたい
- 【特集】
- 首都大学東京教授 木村草太氏に訊く
憲法と平和とこれから─医学生のための憲法教室 - 【CLOSE UP】
- 「被災地」の5年後 原発事故が壊したもの 伝えられない福島
- 【連載】
- 羅針盤'16─医療への長い航海に旅立つ君たちへ 患者さんとともに歩む医師を目指して
- 【医療研究室】
- エレガントな解法─完全側臥位法
- 【特集】
- 医師 莇 昭三氏に訊く 戦後70年 戦争体験から学ぶ“二度と戦争は起こさない”ために…
- 【CLOSE UP】
- “見えにくい”を変える医療現場の試み~医療現場から「子どもの貧困」にせまる~
- 【新連載】
- 羅針盤'15-医療への長い航海に旅立つ君たちへ-
- 【医療研究室】
- DMORT(災害時遺族・遺体対応派遣チーム)
- 【特集】
- 医師 本田 宏氏に訊く 医師になる前に知ってほしい、日本の医療の現状
- 【CLOSE UP】
- 支え合う災害医療 ~被災者に寄り添って見えてくること~
- 【医療研究室】
- 若年2型糖尿病の実態 民医連「暮らし・仕事と糖尿病全国調査」報告
- 【連載】
- 産婦人科医かずこ先生の課外授業 16 最終回
- 【特集】
- 医師と医学生が本気で議論する戦争と平和
- 【CLOSE UP】
- これからの医学教育を、考える
- 【連載】
- 産婦人科医かずこ先生の課外授業 15
- 【医療研究室】
- インターネット依存症について
- 【特集】
- 地域包括ケア時代に求められる医師
- 【CLOSE UP】
- 生活と労働から疾病をとらえる医療
- 【連載】
- 産婦人科医かずこ先生の課外授業 14
- 【医療研究室】
- 黒麹菌を原因とした急性過敏性肺炎、診断から職場とのやり取りについて
- 【特集】
- 国境なき医師団/黒崎伸子会長に聞く
医師を目指すあなたに知ってほしいこと - 【CLOSE UP】
- start my doctor life ~患者さんから学ぶ、社会から学ぶ~
- 【連載】
- 産婦人科医かずこ先生の課外授業 13
- 【医療研究室】
- 無料低額宿泊所に住む患者の生活と健康に及ぼす影響について
- 【特集】
- 医師/中村 哲氏に訊く
『憲法を、説く』─真の信頼は非武装から生まれる─ - 【CLOSE UP】
- 今、医学教育を考える ECFMG2023年問題を知っていますか
- 【連載】
- 産婦人科医かずこ先生の課外授業 12
- 【医療研究室】
- 若年2型糖尿病の実態 民医連「暮らし・仕事と糖尿病全国調査」中間報告
- 【特集】
- 法政大学社会学部教授/水島
宏明氏に訊く
メディアを見る目 ―テレビが伝えたこと、伝えないこと - 【CLOSE UP】
- 私たちが目指すもの ― 編集員が行く!新・民医連綱領を知らせ隊
- 【連載】
- 産婦人科医かずこ先生の課外授業 フィールドワーク編
- 【レポート】
- 編集員レポート ― 新専門医制度のゆくえ
- 【特集】
- 経済アナリスト/森永卓郎氏に訊く
どうなる日本社会~医学生に知ってほしいTPPと消費税増税~ - 【CLOSE UP】
- 「医師として生きる」ということ
- 【連載】
- 産婦人科医かずこ先生の課外授業 11
- 【医療研究室】
- 身近なことから臨床研究へ
- 【特集】
- 医師/鎌田 實氏に訊く
みて 感じて 動く~見て見ぬふりをしない~ - 【CLOSE UP】
- “医志"あるあなたへ、伝えたいこと
- 【連載】
- 産婦人科医かずこ先生の課外授業 8
- 【医療研究室】
- 卒後臨床研修評価を知っていますか?
- 【特集】
- Report 「3.11」その後
生活に根ざした復興 ─医学生が訪れた大船渡─ - 【不定期連載】
- 私たちが目指すもの ─編集員が行く ! 新・民医連綱領を知らせ隊─
- 【連載】
- 産婦人科医かずこ先生の課外授業 7
- 【医療研究室】
- 統計解析を臨床に役立てる
- 【特集】
- 前宜野湾市長/伊波 洋一氏に訊く
「ノー」と言い続けることが力になる ─ 沖縄から基地をなくそう─ - 【不定期連載】
- 私たちが目指すもの ─編集員が行く ! 新・民医連綱領を知らせ隊─
- 【連載】
- 産婦人科医かずこ先生の課外授業 6
- 【レポート】
- 東日本大震災 ─ 医学生のボランティア日記
- 【医療研究室】
- ホスピス緩和ケアを広げよう
- 【特集】
- New Year Special
医師/日野原重明
医師の使命 ─学び、活かし、伝える─ - 【CLOSE UP】
- あなたは誰のために、何のために医師を目指しますか
- 【連載】
- 産婦人科医かずこ先生の課外授業 5
- 【医療研究室】
- HPHについて
- 【特集】
- ノーベル物理学賞受賞/益川敏英先生に訊く
研究のこと平和のこと - 【CLOSE UP】
- 長崎民医連 坂のある町に暮らす
在宅医療・介護を支える長崎民医連の取り組み - 【連載】
- 産婦人科医かずこ先生の課外授業 4
- 【緊急特集】
- 「自殺も考える」深刻な医学部生の留年問題
- 【特集】
- 『子どもの貧困』著者/阿部
彩氏に訊く
子どもたちを社会で育てよう ─他人事じゃない、子どもの貧困─ - 【CLOSE UP】
- 患者に学ぶ 日常診療から生まれたERHSE
- 【連載】
- 産婦人科医かずこ先生の課外授業 3
- 【医療研究室】
- 日常診療の問題点から出発して
- 【特集】
- New Year Special
写真家/寺島萬里子
常に民衆のために ─医師として、写真家として─ - 【CLOSE UP】
- 今なお続く水俣病被害 ─真実を明らかにした水俣大検診─
- 【連載】
- 産婦人科医かずこ先生の課外授業 2
- 【医療研究室】
- 「私の意思書」家族と話し合うリビングウイル
- 【特集】
- 千葉大学名誉教授/三輪定宣氏に訊く
学ぶ幸せをつかみとろう─学費無償化は世界の流れ - 【CLOSE UP】
- いのちの平等を求めて ─尼崎医療生悔の無料低額齢療のとりくみ─
- 【連載】
- 産婦人科医かずこ先生の課外授業 1
- 【医療研究室】
- 小規模病院はプライマリケアの宝庫だ
- 【特集】
- REPORT/民医連キューバ医療視察団
2009.1
キューバ医療─人を大切にする社会─ - 【CLOSE UP】
- のどかな風景の裏で… ─医療崩壊に直面する京都府北部の民医連で、今。─
- 派遣村って他人事ですか?
- 【医療研究室】
- 外来化学療法の実践
- 【特集】
- 精神科医/香山リカ氏に訊く
─ 悩める時代に ─視点を外に向けて… - 【CLOSE UP】
- 患者とともに生きる ─必要とされる医療を必要とされるところで─
- 【連載】
- 医師夫婦ってどうよ? 6
- 【医療研究室】
- 東京大気汚染公害裁判に関わった医師として
- 【特集】
- NPO法人自立生活サポートセンターもやい事務局長/湯浅 誠氏に訊く
見えないものを視る─日本を蝕む貧困という病い─ - 【CLOSE UP】
- 人の役に立ちたくて選んだ道 ─産婦人科で輝く青年医師─
- 【連載】
- 医師夫婦ってどうよ? 5
- 【医療研究室】
- 市中感染症とたたかう
- 【特集】
- 『パッチギ!』の井筒和幸監督に訊く
知力を磨け! - 【CLOSE UP】
- 地域の中で育つ医師─青年医師が担う診療所─
- 【連載】
- 医師夫婦ってどうよ? 3
- 【医療研究室】
- 社会環境、労働環境と糖尿病との関係
- 【特集】
- 東京大学大学院教育学研究科教授 日本教育学会
会長/佐藤 学先生にに訊く
プロフェッショナルを育てる─教養教育の持つ意味─ - 【CLOSE UP】
- 大泉生協病院 地域の小児科は今
- 【連載】
- Dr.なちこの「おもっしぃ日記」最終回
- 【医療研究室】
- 原爆症認定訴訟の争点となる残留放射線の評価
- 【特集】
- 法学館館長 伊藤塾塾長/伊藤
真先生に訊く
ひとりひとりを大切にするもの─日本国憲法の価値─ - 【CLOSE UP】
- 働くものの"いのち"を守る医師を目指す
- 【連載】
- Dr.なちこの「おもっしぃ日記」03
- 【医療研究室】
- 未成年禁煙外来
- 【特集】
- 『健康格差社会』の著者/近藤克則先生に訊く
医療は、権利か?サービスか?? - 【CLOSE UP】
- This is the “Izu-mode"!「病棟もみる家庭医」の養成~日本で4番目の家庭医療学センター~
- 【連載】
- Dr.なちこの「おもっしぃ日記」02
- 【医療研究室】
- アスベストによる健康障害
- 【特集】
- PMS(ペシャワール会医療サービス)総院長/中村 哲先生に聞く
必要とされる場所で必要に応えられる医師に - 【CLOSE UP】
- 緩和ケアとは?
- 【連載】
- Dr.なちこの「おもっしぃ日記」01
- 【医療研究室】
- 模擬患者会(SP)の活動
- 【特集】
- 李啓充先生に聞く
日本医療の“光"と“翳り" ~アメリカ医療から何を学ぶべきか~ - 【CLOSE UP】
- 健生ER ~津軽地域の救急に全力で応える~
- 【連載】
- 南国通信 きゅうがめ~ら! 05
- 【医療研究室】
- 精神科医療現場の話題から 「パチンコ依存症」
- 【特集】
- 医者として生きる -医師の使命と幸せ
- 【CLOSE UP】
- 初期研修における整形外科研修の役割
- 【連載】
- 南国通信 きゅうがめ~ら! 04
- 【医療研究室】
- なぜ、民医連は平和活動に取り組むのか
- 【特集】
- 真実を見極める確かな目を持って
- 【CLOSE UP】
- わたしの生き方を決めた阪神・淡路大震災
- 【連載】
- 南国通信 きゅうがめ~ら! 03
- 【医療研究室】
- 栄養サポートチームの役割と課題
- 【特集】
- 池田香代子さんインタビュー
今から私たちができること
- 【CLOSE UP】
- 「先生まってたざ~」
- 【連載】
- 南国通信 きゅうがめ~ら! 02
- 【医療研究室】
- 褥瘡治療の新しい展開
- 【特集】
- 誇るべきは平和憲法
- 【FOCUS ON】
- 2004年卒後研修必修化…キミはどうする!? 第6弾
- 【新連載】
- 南国通信 きゅうがめ~ら! 01
- 【医療研究室】
- 内視鏡的胃癌切除術、切開・剥離法
- 【特集】
- 癒す心を忘れないで
- 【FOCUS ON】
- 2004年卒後研修必修化…キミはどうする!? 第5弾
- 【医療研究室】
- 主治医の力量、スタッフの観察眼が問われる疥癬の診断
- 【特集】
- 医療費の患者負担増が「命綱」を切る
「病人」になれない国、日本 - 【FOCUS ON】
- 2004年卒後研修必修化…キミはどうする!? 第4弾
- 【連載】
- ひろみの笑いと涙の研修日記 06
- 【医療研究室】
- 21世紀の国民病・睡眠時無呼吸症候群(SAS)
- 【特集】
- イラク戦争のあとで―
私たちは世界を変えたい!
We Need Peace
- 【FOCUS ON】
- 2004年卒後研修必修化…キミはどうする!? 第3弾
- 【連載】
- ひろみの笑いと涙の研修日記 05
- 【医療研究室】
- 心拍再開率が一変!ACLSコース
- 【特集】
- Special Interview
辺見庸さんと語る
いま、言葉にしよう! - 【FOCUS ON】
- 2004年卒後研修必修化…キミはどうする!? 第2弾
- 【連載】
- ひろみの笑いと涙の研修日記 04
- 【医療研究室】
- 「合併症で倒れないための大運動会」は合併症を半減させたか
- 【特集】
- 構造改革を斬る!
- 【FOCUS ON】
- 2004年卒後研修必修化…キミはどうする!?
第1弾
基本的診療能力の獲得をめざして - 【新連載】
- ひろみの笑いと涙の研修日記 03
- 【医療研究室】
- B型肝炎とC型肝炎
- 【特集】
- 地域にかける医療
- 【FOCUS ON】
- 2年目研修医、初めての学会!ガッカイ
- 【新連載】
- ひろみの笑いと涙の研修日記 02
- 【医療研究室】
- 児童虐待防止ネットワークと医師の役割
- 【特集】
- 坂道の街から
- 【FOCUS ON】
- INTERVIEW
ハンセン病元患者・谺雄二さん - 【新連載】
- ひろみの笑いと涙の研修日記 01
- 【医療研究室】
- 紙カルテの限界を打破・医療情報システムのIT化
- 【特集】
- 医療の安全
いのちと権利を守るために - 【FOCUS ON】
- REPORT
女性医師、語る「Be myself 自分らしい生き方で」 - 【連載】
- Dr.えつこの夫の日記 2
- 【医療研究室】
- 患者さんの命と健康、人権を守るために
- 【特集】
- 臨床研修の現場から
研修医奮闘記 - 【FOCUS ON】
- REPORT
ベトナム枯葉剤被害調査2001 - 【連載】
- Dr.えつこの夫の日記 1
- 【医療研究室】
- 医学・医療における knowledge management
- 【特集】
- 柳田邦男さん・医学生によせる思い
壁を貫く意志を持て
- 【CLOSE UP】
- 北海道民医連・上砂川診療所から
笑顔をたやさず、いつも身近に - 【連載】
- Dr.えつこの日記 4
- 【医療研究室】
- 教訓を生かすために何が必要なのか
セラチア菌院内感染についての報告 - 【特集】
- 医学教育はだれのためにあるのか…2
学びの現実とそこにある可能性
- 【FOCUS ON】
- 地球上から核兵器をなくそう
リポート IPPNW2000 in Paris - 【連載】
- Dr.えつこの日記 3
- 【医療研究室】
- 副作用被害から患者さんを守るために
- 【特集】
- 医学教育はだれのためにあるのか
学びを自分たちのものにしよう! - 【CLOSE UP】
- 汐田・脳とこころのクリニックから
ひとづくり、まちづくりの拠点になりたい - 【連載】
- Dr.えつこの日記 2
- 【医療研究室】
- 古くて新しい感染症・結核
- 【特集】
- 人として医師として
何を学び、どう生きるか。 - 【FOCUS ON】
- 21世紀の日本と大学があぶない!
- 【連載】
- Dr.えつこの日記 1
- 【医療研究室】
- 老人性難聴と補聴器の公的支給のとりくみ
- 【特集】
- いま求められている医師の社会的使命とは
- 【FOCUS ON】
- 2000年、国試がこう変わる!
- 【医療研究室】
- 胃癌予防のカギ Helicobacter pylori
- 【特集】
- ここからつながるすべての生命たちへ
Think globally. Actlocally.
- 【FOCUS ON】
- 3万人の実態が見えてきた!
要介護老人調査が語るもの - 【CLOSE UP】
- あなたの卒業臨床研修をぜひ診療所で!
- 【医療研究室】
- リストラ、労働強化…平成不況から命を守りたい!
過労死 - 【特集】
- 医療の入口に立った君たちへ
21世紀、何を学びどう生きるか - 【FOCUS ON】
- 診察室から"リストラ"が見える不況と医療
- 【連載】
- Dr.まりこの IPPNW世界大会inメルボルン!
- 【医療研究室】
- きわめて単純な病気に感じる奥深さ 内痔核
- 【特集】
- インターカレッジ【AMSA】に聞く
医療と福祉のすき間から
見えたよ介護問題 - 【FOCUS ON】
- セミパラチンスクの悲劇 核は生命に何をしたのか!?
- 【連載】
- Dr.まりこの リハ科に研修医がやってきた!
- 【医療研究室】
- 低線量被曝の意味
【2025 Vol.93 AUTUMN】New
【2025 Vol.92 SUMMER】
【2025 Vol.91 SPRING】
【2024 Vol.90 AUTUMN】
【2024 Vol.89 SUMMER】
【2024 Vol.89 SUMMER】
【2024 Vol.88 SPRING】
【2024 Vol.87 AUTUMN】
【2023 Vol.86 SUMMER】
【2023 Vol.85 SPRING】
【2022 Vol.84 AUTUMN】
【2022 Vol.83 SUMMER】
【2022 Vol.82 SPRING】
【2021 Vol.81 AUTUMN】
【2021 Vol.80 SUMMER】
【2021 Vol.79 SPRING】
【2020 Vol.78 AUTUMN】
【2020 Vol.77 SUMMER】
【2020 Vol.76 SPRING】
【2019 Vol.75 AUTUMN】
【2019 Vol.74 SUMMER】
【2019 Vol.73 SPRING】
【2018 Vol.72 AUTUMN】
【2018 Vol.71 SUMMER】
【2018 Vol.70 SPRING】
【2017 Vol.69 AUTUMN】
【2017 Vol.68 SUMMER】
【2017 Vol.67 SPRING】
【2016 Vol.66 AUTUMN】
【2016 Vol.65 SUMMER】
【2016 SPRING 特別号】
憲法はそもそも国民の義務をさだめたものではない。国民が権力者による恣意的な政治を禁じ、その手をしばるためのものだ。昨年秋、多くの学者が戦争法の違憲性を指摘した。空前の規模の人々が国会前を埋めつくした。 国会を取り巻いたSEALDsの学生たちは、「民主主義ってなんだ!」「これだ!」と叫んだが、その声は安倍さんには届かなかった。この国の民主主義は危機に瀕している。法律が成立した今、民主主義を取り戻すFirst Actionは、戦争法を廃止することだ。
![研修医、医学生に役立つ情報・イベント・病院実習・コラム・奨学金情報などが満載! 全日本民医連医師臨床研修センター [aequalis(イコリス)]](/common/images/logo.png)